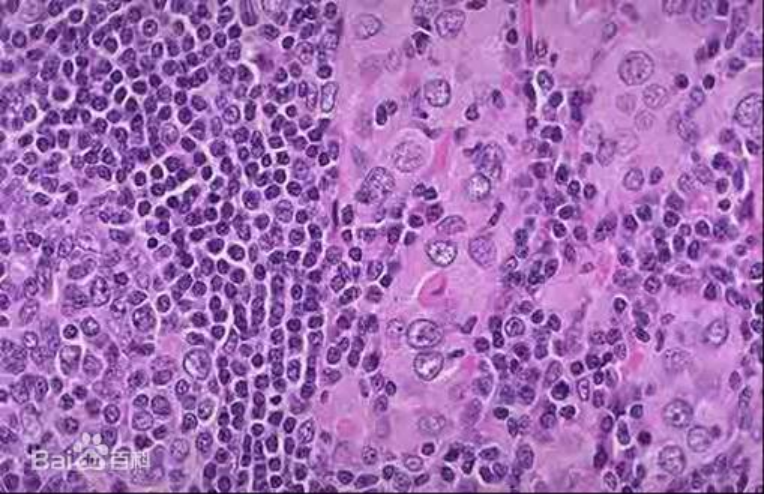

前两天在门诊接诊一位女性患者,患者开门见山说道:“医生,你看我这是癌症吗”,接过患者手中的B超和化验单,原来是甲状腺结节,再看甲功能,还正常。我安慰道:“离癌症还远着呢”患者回答道“那就好,中医药可以治疗吗?”“可以的”,吃完两二月中药和中成药后,复查B超提示结节缩小至一半。该患者露出开心笑容,说自己以后可以安心睡觉了。
体检中经常发现结节,很多患者心里就担心,是癌症吗?是啊,在这个谈癌色变的年代,看到体检单中的结节,我心里也难免不担心。而女性患者最多的莫过于乳腺和甲状腺结节了。今天,我们就聊聊甲状腺结节的那些事。
甲状腺结节或肿块、甲状腺肿大是其主要症状,除此外大多数甲状腺结节患者没有临床症状,可通过自我触摸或体格检查发现甲状腺有结节,或因甲状腺肿大就诊,进行查体或B超等影像学检查获知。

甲状腺结节临床极为常见,常见于女性。甲状腺结节多为良性,恶性结节仅占甲状腺结节的0.1%左右。是癌吗?目前看来女性朋友大可不必担心。
医生,我为什么就得了这个甲状腺结节病呢包括我周围的闺蜜。而不是我家那口子呢?也是啊,甲状腺结节病为什么就与多与女性朋友过不去呢?而不是男性朋友呢。
(1)中医认为女子以肝为先天,甲状腺正好在肝经循行处,而肝主情志,女性患者容易情绪波动,肝气郁结,形成结节,因此女性患者为多。
(2)生活节奏快,压力大。
(3)饮食不规律。
(4)部分患者与遗传有关。
(5)精神创伤,过度劳累。

医生既然大多数都是良性结节,恶性结节该如何识别呢?
好,下面我们来看看甲状腺恶性结节的真面目
(1)年龄小于20岁或大于70岁(青少年甲状腺结节中甲状腺痛占40%一60%)。
(2)男性(女性甲状腺结节发病率为男性的8倍,但甲状腺癌发病率仅为其2一3倍)。
(3)有颈部放射线检查治疗史(放疗后3一5年即可发病,但高峰在15一30年)。
(4)有甲状腺髓样癌或多发性内分泌腺瘤病2型家族史。
(5)结节增长迅速,且超过2 cm(除外良性腺瘤出血)。
(6)伴有疼痛及持续性声音嘶哑、发音困难、吞咽困难和呼吸困难。
(7)结节质地硬、形状不规则、粘连固定。
(8)伴颈部淋巴结肿大。
医生,这也太多太复杂了,分不清楚啊,有好的办法吗?

有啊,可以借助B超,验甲功,如果医生也拿不定主意,还可以借助细针穿刺这个火眼金睛,帮我们看看这个结节里面细胞的真面目。
还好,我不是恶性甲状腺结节。但是,我颈部总是不舒服,颈部胀闷憋气咽部有阻塞感。我该怎么办呢?
一般来说,甲状腺结节不需要治疗,但是一旦伴有颈部不适,心悸,汗出等,需要进行干预。现代医学一般定期复查,必要时手术干预。
医生,我不能手术啊,因为我是疤痕体质,手术后留下的疤痕,会吓到你的。
那好,可以到北京中医大学深圳医院(龙岗)肿瘤康复中心
我中心目前不但对甲状腺结节,包块肺结节,息肉,多发性脂肪瘤等,形成了特色疗法。
(1)中药辨证论治,运用古方灵活加减,疗效突出。
(2)运用民间针法董氏奇穴,针药结合,起到1+1>3的效果
